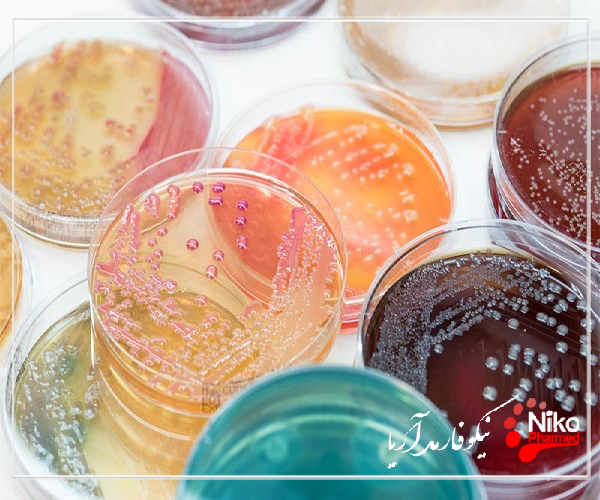
پلیت های آماده میکروبی m/پلیت های آماده میکروبی

پلیت های آماده میکروبی
پلیت های آماده میکروبی؛ در محیط جامد، یک میکروب منفرد رشد می کند و تقسیم می شود تا یک " یک نقطه از فرزندان یکسان " تولید کند،. انواع مختلف میکروب ها کلونی هایی با ویژگی های متفاوتی مانند شکل، رنگ، بافت تولید می کنند که به میکروبیولوژیست ها کمک می کند تا مشخص کنند آیا یک کشت خالص است یا اینکه انواع میکروب ها را در یک نمونه مخلوط شناسایی کنند.
برای کسب اطلاعات بیشتر و دریافت خدمات با ما تماس بگیرید.
تعدادی از شرکت های عرضه کننده بیولوژیکی بشقاب های از پیش ساخته شده را می فروشند، اما ساختن خودتان هزینه بسیار کمتری دارد. با کمی تمرین متوجه خواهید شد که ساخت بشقاب های خود بسیار آسان است و انعطاف پذیری بیشتری خواهید داشت که بتوانید دستور العمل ها را مطابق با نیازهای خود سفارشی کنید.
_1. نوع آن را انتخاب کنید
یک دستور نوع دلخواه را از صفحه دستور العمل های رسانه انتخاب کنید.
تصمیم بگیرید که به چه تعداد از بشقاب ها را نیاز دارید. دستور العمل های ما 1 لیتر (1000 میلی لیتر) محیط تولید می کند که برای پر کردن تقریباً چهل بشقاب 100 میلی متری کافی است، اما در صورت نیاز می توان آن ها را کم یا زیاد کرد.
برای استفاده از حدود 25 میلی لیتر در صفحه 100 میلی متر برنامه ریزی کنید.
_2. وسایل را جمع آوری کنید
مواد اولیه دستور نوع آن
ظروف پتری استریل، پلی استایرن. 100 در 15 میلی متر رایج ترین اندازه است، اما اندازه های 60 و 35 میلی متر نیز کار می کنند.
ظرف شیشه ای که حداقل دو برابر حجم رسانه شما را در خود جای می دهد
فویل آلومینیومی برای پوشاندن ظروف رسانه ای یا پوشش پلاستیکی اگر از مایکروویو استفاده می کنید
اتوکلاو، زودپز، مایکروویو یا صفحه داغ برای استریل کردن محیط
دستکشهای مقاوم در برابر حرارت، دستکشها برای جابجایی ظروف داغ
70٪ اتیل یا ایزوپروپیل (مالش) الکل
پاک کننده خانگی، 10% سفید کننده یا دستمال مرطوب ضد عفونی کننده برای تمیز کردن محل کار شما
سیلندر مدرج برای اندازه گیری آب
تعادل برای توزین مواد جامد
ابزارهایی برای جابجایی مواد جامد (مانند قایق های وزن کشی و اسکوپولا یا بشقاب ها و قاشق های کاغذی)
_3. رسانه را آماده کنید
از یک ظرف شیشه ای (به طور ایده آل یک فلاسک ارلن) استفاده کنید که حداقل دو برابر حجم رسانه شما را در خود جای دهد.
مواد را طبق دستور مورد نظرتان جمع کنید.
اگر از مایکروویو استفاده می کنید، آن را با فویل آلومینیومی یا پوشش پلاستیکی بپوشانید.
_4. استریل کنید
با استفاده از یکی از روش های توضیح داده شده در صفحه مایعات استریل کنید.
یکی از مزایای محیط های پر نمک این است که میکروب های آلوده معمولی روی آن رشد نمی کنند، بنابراین محیط هایی با غلظت نمک حداقل 10 درصد را می توان با جوشاندن استریل کرد.
مطمئن شوید که آگار کاملا حل می شود. در محیط های حاوی 15 درصد نمک یا بیشتر، آگار ممکن است دیر حل شود.
رسانه ممکن است ابری به نظر برسد، یا ممکن است اجسام عدسی مانند کوچک و نیمه شفافی را ببینید که در آن شناور هستند.
به جوشیدن ادامه دهید تا محیط کاملاً شفاف شود. این ممکن است بیش از 15 دقیقه طول بکشد. آگاری که به طور کامل حل نشده باشد، رسانه شما را لطیف یا شکننده می کند.
مقالات بیشتر:
تولید رسانه آماده به خودی خود یک تجارت است
تولید واقعی صفحات آگار، به خودی خود، چندان پیچیده نیست. با این حال، اطمینان از کیفیت ثابت محصول برای همه مشاغلی که به استفاده از آن متکی هستند بسیار مهم است. عدم انجام این کار می تواند باعث خوانش نادرست شود که می تواند کل تجارت را به خطر بیندازد یا در بدترین موارد منجر به مرگ و میر شود.
اگر فرهنگ رسانه ای تهیه شده از کیفیت پایینی برخوردار باشد. به درستی ذخیره نشده است؛ آلوده بوده یا برای شروع مناسب تشخیص داده نشده است. هر آزمایشی که با استفاده از آن رسانه انجام شود، نتایج غیر قابل اعتمادی ارائه خواهد داد.
تنها راه برای اطمینان از قابل اعتماد بودن رسانه شما، ایجاد آن با استفاده از روش های قابل اعتماد است. تولید رسانه های آماده صنعتی است که به شدت تحت نظارت است. معمولاً انتظار می رود که تأمین کنندگان استانداردهای ISO را رعایت کنند و گواهینامه های فعلی را که نشان دهنده انطباق است، داشته باشند. این مقررات برای اطمینان از تولید رسانهها با کیفیت بالا وضع شدهاند و در شرایطی که برای حفاظت از عموم نیاز به خواندن دقیق دارند، میتوان به آنها اعتماد کرد.
تنها راه برای اطمینان از اینکه رسانههای آماده داخلی شما میتوانند با محصول ماهرانهای رقابت کنند، این است که از متخصصان بیاموزید و بهترین شیوههای آنها را مانند خودتان بپذیرید.
5 نکته کلیدی متخصص در تولید رسانه های کشت با کیفیت خوب
- اطمینان حاصل کنید که زیرساخت مناسب در ابتدا وجود دارد
راه اندازی زیرساخت مناسب اولین قدم مهم شماست. شما به یک محیط آزمایشگاهی نیاز دارید که در شرایط آسپتیک نگهداری شود، با فرآیندهایی که تضمین می کند می توانید همیشه از استریل و تمیزی محیط آزمایشگاه پشتیبانی کنید. عدم رعایت بالاترین استانداردها در تهیه محیط کشت می تواند بر تمام آزمایشات بعدی که برای آنها استفاده می شود تأثیر بگذارد. راه اندازی این می تواند پرهزینه باشد، اما بدون زیرساخت مناسب، کل عملیات خود را در معرض خطر قرار می دهید.
- هرگز با مواد اولیه نامرغوب یا کارکنان آموزش ندیده کار نکنید
اگر با مواد اولیه بی کیفیت شروع کنید، نمی توانید یک محصول نهایی با کیفیت خوب ایجاد کنید. اطمینان از اینکه شما همیشه از مواد با بالاترین کیفیت استفاده می کنید با یافتن یک تامین کننده واجد شرایط با زنجیره تامین واجد شرایط شروع می شود. ضروری است که برای هر دسته از مواد در هنگام تحویل، بازبینی گواهی های تجزیه و تحلیل انجام شود. منبع آب غیر معدنی شما نیز باید به دقت کنترل، نظارت و نگهداری شود. علاوه بر این، کارکنان آزمایشگاه شما باید در تمام مراحل آماده سازی آموزش دیده باشند و تمام پروتکل های تمیز کردن شما باید معتبر باشد.
- تجهیزات خود را کالیبره و استریل نگه دارید
فهرست گسترده ای از تجهیزات ضروری شما شامل تلگراف، اتوکلاو، کابینت جریان هوای آرام و PH متر است. تمام تجهیزات باید کالیبره شده، برای استفاده خاص خود واجد شرایط باشند و در صورت لزوم دارای تعمیر و نگهداری پیشگیرانه برنامه ریزی شده (PPM) باشند. همه ظروف باید استریل بوده و از تامین کنندگان تایید شده ای که استانداردهای انطباق را دارند تهیه شده باشد.
استحکام بسته بندی نیز از اهمیت حیاتی برخوردار است. باید در طول مدت ماندگاری دست نخورده باقی بماند تا محصول استریل بماند. تمام مناطقی که محیط استریل تولید و نگهداری می شود باید از نظر محیطی نظارت شود. واحدهای جریان هوای آرام باید فیلترهای HEPA و جریان هوا را به عنوان بخشی از روش های PPM شما به طور مرتب بررسی کنند.
- کنترل کیفیت را در اولویت قرار دهید
برای اطمینان از عملکرد مطلوب رسانه، به یک رژیم کنترل کیفیت قوی نیاز دارید. کنترل کیفیت رسانه ای که تولید می کنید از طریق استریل بودن، مواد با کیفیت و فرآیندهای اعتبارسنجی بسیار مهم است. بررسی های قبل از انتشار قبل از استفاده حیاتی است و نظارت مستمر محیطی مورد نیاز است. اگر بالاترین استانداردها را در زمینه آماده سازی رسانه های فرهنگی خود رعایت نکنید، می توانید تمام آزمایش های آینده خود را در معرض خطر قرار دهید. اشتباه کردن در اقدامات کنترل کیفیت از همان ابتدا، می تواند منجر به زنجیره ای از رویدادهای آلودگی شود که حتی می تواند منجر به عواقب کشنده شود. در طول فرآیند تولید شما، آزمایش، نظارت و کنترل باید انجام شود.
- راهبردی بیابید که ثبات را تضمین کند
کیفیت برتر رسانه های آماده ای که تولید می کنید باید ثابت بماند. در غیر این صورت، آزمایش شما و داده های به دست آمده از فعالیت های رسانه های فرهنگی قابل اعتماد نیست. این بدان معنی است که رسانه آماده شما باید به طور منظم تحت آزمایش های دقیق قرار گیرد، زیرا این تنها راه برای اطمینان از کیفیت حرفه ای مداوم است.
فرآیند انتقال نمونههای گرفتهشده از محیطی که حاوی میکروارگانیسمهایی است یا وجود آنها بررسی میشود، با کمک ابزار کاشت، تحت قوانین خاصی به محیط کشت «کاشت» میگویند.

قوانین کلی روش کاشت;
- به منظور جلوگیری از جریان هوا در اتاق کاشت، اتاق کار باید بسته نگه داشته شود.
- کاشت باید همیشه در کنار شعله انجام شود.
- نمونه های کاشت و محیط کشت باید در محلی قرار داده شود که بتوان به راحتی آنها را برداشت و رها کرد.
- قبل از شروع کاشت باید با قلم شیشه ای یا به روش لیبل، تاریخ نمونه کاشت و چیستی آن را روی محیط کشت بنویسید.
- اگر قرار است نمونه از محیط مایع برای کاشت گرفته شود باید از حلقه، پیپت پاستور، پاک کن و اگر نمونه از محیط جامد گرفته شود باید از حلقه سوزنی استفاده کرد.
کاشت در محیط جامد
بذور از کشت های مایع یا جامد تا محیط های آبکاری شده.
کاشت برای کاهش مستعمره
کاشت متقاطع در هر خراش. این روش زمانی است که در نمونه مقدار متوسطی از باکتری وجود دارد.
کاشت با تلاقی در اولین خراش. در صورت وجود تعداد زیادی باکتری در نمونه کاشت از این روش استفاده می شود.
کاشت زیگزاگ؛ در صورت وجود تعداد کمی باکتری در نمونه کاشت از این روش استفاده می شود.
- هدف از کاشت تک کلنی تولید کلنی های میکروارگانیسم هایی است که باید جدا از سایر کلنی های باکتری روی سطح صفحه کاشته شوند.
– برای جداسازی و شناسایی میکروارگانیسم عامل بیماری در نمونه کاشت از سایر میکروارگانیسم های موجود در نمونه، ابتدا باید یک کلنی منفرد به دست آید.
– نمونه کاشت با استفاده از تکنیک کاشت تک کلنی (رقیق سازی) به کمک حلقه در سطح محیط پلیت کاشته می شود. در کاشت تک کلنی، اولین نواحی کاشت محیط حاوی باکتری های زیادی است، در حالی که منطقه کاشت آخر حاوی باکتری های بسیار کمی است که از یکدیگر دور هستند.
– باکتری هایی که به طور جداگانه در محیط صفحه سقوط کرده اند، به طور مستقل از سایر باکتری ها تولید مثل می کنند و ساختارهای کلونی معمولی مناسب برای ساختار ژنتیکی باکتری ها و ویژگی های گونه را تشکیل می دهند.
- مقالات بیشتر:
- تست چسبندگی سلولی
- مشاوره جهت ساخت اتاق تمیز
- مشاوره جهت تهیه تکنیکال فایل
- تست خون سازگاری و هولیز کنندگی
- تشخیص اشرشیا کلی در محصولات پزشکی
- تشخیص استاف در محصولات پزشکی
روش صفحه پخش
این روش کاشت برای آزمایش آنتی بیوگرام و شمارش باکتری های موجود در ادرار است. هدف از کشت گسترده در سطح صفحه اطمینان از تولید مثل گسترده میکروارگانیسم هایی است که در نمونه کشت در کل سطح محیط صفحه یافت می شود.
خواص رسانه مورد استفاده در کاشت گسترده
– از رسانه های از پیش آماده شده استفاده می شود.
– باید به نسبت خشکی و رطوبت سطح متوسط توجه شود. کاشت در محیط هایی که سطح آنها خیلی خشک یا خیلی مرطوب است انجام نمی شود.
– محیط پلیت مناسب برای نمونه کاشت انتخاب شود و قبل از کاشت صبر کرد تا به دمای اتاق برسد.
– در روش صفحه اسمیر ترجیح داده می شود که نمونه کاشت مایعی که قرار است روی سطح بستر پخش شود نسبت به سایر روش های کاشت خشک تر از حد معمول باشد تا سریعتر خشک شود.
بذرهای حاصل از کشت مایع یا جامد به محیط های افقی جامد در لوله ها.
کاشت خط
سوزن حامل نمونه برای تلقیح در محیط جامد شده در حالت خوابیده در لوله ابتدا با حلقه تا پایین ترین نقطه محیط های داخل لوله بدون تماس با چیزی وارد می شود سپس با لمس سطح در امتداد یک خط به عقب کشیده می شود. از رسانه های روی خط وسط بدون اینکه در محیط فرو بروند. باکتری ها نیز در امتداد این خط در نتیجه جوجه کشی رشد می کنند.
کشت سطحی در بستر مسطح
ابتدا کاشت لاین انجام می شود. سوزن مجدداً تا پایین ترین نقطه بدون خارج شدن از لوله وارد می شود. بدون غوطه ور شدن مجدد در محیط روی سطح محیط، حلقه به آرامی به سمت عقب کشیده می شود که از خط وسط به صورت زیگزاگ عبور می کند.
کاشت نقطه ای روی سطح محیط جامد افقی
کاشت از کشت های مایع یا جامد بر روی محیط های جامد عمودی در لوله ها.
کاشت نقطه ای روی سطح عمودی جامد.
فرهنگ غوطه وری
کاشت با حلقه سوزنی انجام می شود. سوزن حامل باکتری که قرار است کاشته شود در محیطی که در حالت عمودی در لوله جامد شده است، وارد محیط می شود و بدون تماس با هسته خارج می شود. پس از انکوباسیون، تولید مثل در امتداد خط غوطه وری رخ می دهد.
فرهنگ آژیتاسیون
محیط جامد با منجمد بالا در لوله ها در یک حمام آب گرم مایع می شود. تا دمای 45-48 درجه سانتیگراد خنک می شود. در همان دما، محیط کشت باکتریایی مایع تلقیح شده و تکان داده می شود. محیط همچنین وقتی سرد می شود جامد می شود.
پیوند به محیط مایع
- کاشت از محیط جامد به محیط مایع.
حلقه سوزن و غیره از رسانه جامد. كشت باكتريايي كه با كمك محيط مايعي كه قرار است كشت شود گرفته مي شود، كمي مايل نگه داشته مي شود.
- کاشت از کشت مایع به رسانه مایع.
با کمک پیپت یا حلقه پاستور ساخته می شود.
آزمون تعیین بار میکروبی|بار میکروبی| پایش میکروبی|تست میکروبی





